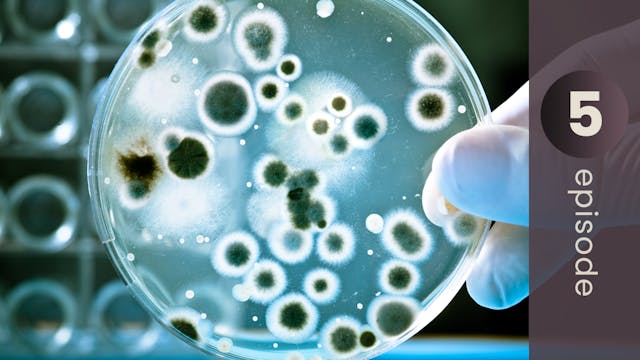
Toxin Detectives: Tests to Uncover th...

Live stream preview
Household Under Siege: The Hidden Toxic Sources of Your Pain, Fatigue, Brain Fog
BEYOND THE BRAIN
•
50m
Episode 2
Up Next in BEYOND THE BRAIN
-
The Wildfire in Your Brain: #1 Cause ...
Episode 3
-
Sick Gut, Sick Brain: Overcoming the ...
Episode 4
-
Toxin Detectives: Tests to Uncover th...
Episode 5